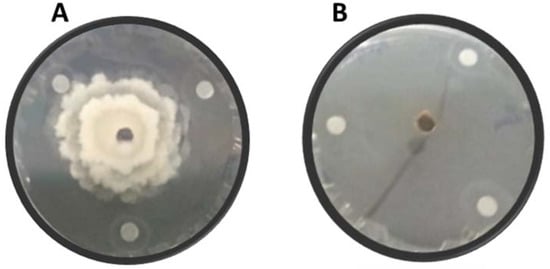

Abstract
After harvest, numerous plant pathogenic fungi can infect fresh fruits during transit and storage. Although synthetic fungicides are often used to manage postharvest fruit diseases, their application may lead to problems such as the development of fungicide resistance and residues on fruits. In the present study, the antifungal potential of nine commercial essential oils (EOs) extracted from Eucalyptus radiata ssp. radiata, Mentha pulegium, Rosmarinus officinalis, Origanum compactum, Lavandula angustifolia, Syzygium aromaticum, Thymus vulgaris, Citrus aurantium, and Citrus sinensis were tested against the apple brown rot fungi Monilinia laxa and Monilinia fructigena at different concentrations in vitro (against mycelial growth and spore germination) and in vivo (on detached apple fruit and in semi-commercial postharvest conditions). In addition, fruit quality parameters were evaluated and the composition of the EOs was characterized by Fourier transform infrared (FT-IR) spectroscopy. In vitro results showed significant antifungal activity of all tested EOs on both fungal species. EOs from S. aromaticum were the most effective, whereby inhibition percentages ranged from 64.0 to 94.7% against M. laxa and from 63.9 to 94.4% against M. fructigena for the concentrations 12.5 and 100 µL/mL, respectively, with an EC50 of 6.74 µL/mL for M. laxa and 10.1 µL/mL for M. fructigena. The higher concentrations tested of S. aromaticum, T. vulgaris, C. aurantium, and C. sinensis EOs significantly reduced spore germination, brown rot incidence, and lesion diameter. Evaluation of the treatments during storage for 20 days at 4 °C on apple fruit quality parameters demonstrated the preservation of the fruit quality characteristics studied (weight loss, total soluble solids, titratable acidity, firmness, and maturity index). FT-IR spectra obtained from all tested EO samples presented characteristic peaks and a high diversity of functional groups such as O–H groups, C–H bonds, and C–C stretching. The EOs examined here may have the potential for controlling postharvest fungal diseases of fruit such as brown rot.
Keywords:
brown rot; essential oils; apple; Monilinia laxa; Monilinia fructigena; quality parameter; FT-IR 1. Introduction
Apples (Malus × domestica L. Borkh) are a member of the Rosaceae family and Spiraoideae subfamily. It is a major cultivated fruit grown widely in temperate regions around the world [1]. In Morocco, apples are grown in an area of about 48,671 ha with a total annual production of 600,000 ton corresponding to an average yield of 20 ton/ha. The major production areas are situated in the High and Middle Atlas, more specifically in the two regions of Daraa-Tafilalt and Fez-Meknes. These locations account for more than half of the country’s apple-cultured area [2]. Part of this production is held in cold storage for prolonged marketing, particularly when large quantities of fruit are harvested over a short period of time [3].
Postharvest fungal rots, caused by Botrytis, Penicillium, Gloeosporium, Fusarium, Alternaria, Mucor, Rhizopus, Aspergillus, and Monilinia species, incite important economic losses in apple production each year [4]. Among these, brown rot, caused by Monilinia laxa, M. fructigena, and M. fructicola, is among the most common and most severe postharvest diseases affecting stone and pome fruits worldwide [5,6]. The brown rot fungi cause blossom blight, twig cankers, fruit rot and fruit mummification in the orchard [7]. The pathogen enters the postharvest environment via latent infections on fruit or as a contaminant on the fruit surface. In the absence of suitable control measures, fruit rot develops and continues to spread during postharvest transit and storage [8,9].
Many conventional control approaches are used to avoid and limit disease development in apple fruit destined for storage, particularly cultural practices. The latter focus on controlling factors affecting the physiological state of the fruit and the creation of mechanical wounds. In various studies, physical treatments such as ultraviolet C (UV-C) radiation, thermotherapy, and ozone treatment have been applied to minimize stone fruit postharvest diseases [10].
Currently, chemical control is the main method for post-harvest disease control, yet various studies have shown the overuse of chemicals and their negative consequences [11]. Hence, it is becoming imperative to develop new biological alternative strategies including microbial antagonists as well as natural antimicrobial substances that can be safe and respectful for the environment [12]. Natural plant products have received particular attention as one of the major non-chemical control alternatives for postharvest fruit diseases [10]. These natural antimicrobial compounds are plant substances derived chiefly from aromatic and medicinal plants. Because of their low toxicity, antimicrobial activity, and low persistence in the environment, they are useful elements to include in alternative products to control postharvest diseases [13,14]. However, there are many practical considerations concerning the commercialization of products based on essential oils (EOs) such as the price of the oil used as active components, the continuous availability of oils in a large amount, and the chemical coherence of the oils [15].
Several studies have indicated that natural product extracts or EOs such as clove, cinnamon, citronella, oregano, palmarosa, anise, thyme, cinnamon leaf, and tea tree oils are effective in controlling fungal development [4,16]. Plants are capable of generating a large range of secondary metabolites with potential activity against pathogens [17]. Among these compounds, more than 3000 EOs are available in the form of mixtures containing secondary metabolites that are identified [18]. EOs are volatile and complex components known for their antibacterial, fungicidal, insecticidal, antioxidant, herbicidal, anti-inflammatory, and medicinal properties [19,20]. EOs and their components have been examined for their antifungal properties by several researchers [21,22,23,24]. Therefore, the present work aimed at identifying EOs with strong antimicrobial activity against Monilinia spp. In this context, we evaluated the in vitro antifungal properties of nine different EOs: Mentha pulegium (L.), Eucalyptus radiata, Lavandula angustifolia, Origanum compactum, Rosmarinus officinalis, Syzygium aromaticum (L.), Thymus vulgaris (L.), Citrus aurantium L. ssp. amara (from the blossom of the bitter orange tree), and Citrus sinensis (L.) obtained through steam distillation by a company in Morocco. The choice of these EOs was based on their certification by the National office of food safety (ONSSA) and their commercial availability. Subsequently, T. vulgaris, C. sinensis, and C. aurantium EOs with high activities were selected to evaluate their effect on wounded apple fruits. In addition, the effect of these EOs on the quality parameters of apple fruits such as weight loss (WL), titratable acidity (TA), total soluble solids (TSS), and maturity index (MI) was investigated. Antifungal activity of commercial EOs was compared to Methyl-thiophanate (1 ppm). This fungicide had earlier shown antimicrobial properties against a large range of postharvest pathogens [25].
2. Materials and Methods
2.1. Origin of Oil Extracts
The essential oils used in this trial were extracted from the leaves and flowers of the aromatic plants. C. sinensis EO was extracted from the peel of the the fruit. E. radiata and S. aromaticum EOs were extracted from flowers and flower buds, respectively. Also, neroli EO was extracted from C. aurantium blossoms. These EOs were obtained by steam distillation from the plants cultivated in the geographical area of Sefrou in Morocco by the company of the agricultural Cooperative “Al Iklil“. The EOs are 100% purified and commercially available for sale and are branded and accredited (ONSSA); N°: 11. 112.18; Lot. N°: OC.BO.02.19.
After the extraction procedure, the EOs were stored at 4 °C in opaque bottles to protect them from air and light until used.
2.2. FT-IR Measurements
The FT-IR absorbance spectrum of the nine EOs tested in the present study was recorded using a Perkin Elmer Spectrum Two Fourier Transform Infrared (FT-IR) spectroscopy instrument. The spectrum was measured in the range from 500 to 4000 cm−1 for the resolution 4 cm−1, with a peak-to-peak signal-to-noise ratio of 9300:1 for 5 s of acquisition. Two microliters of essential oil were placed on the top of a diamond crystal and subjected to an infrared beam with wavelengths ranging from 2.5 to 25 µm. Characteristic FT-IR peak values were obtained, and their functional groups were identified. For spectrum confirmation, each analysis was performed three times.
2.3. Fungal Material
The fungal species used to evaluate the antimicrobial activity of the EOs were M. laxa (SPSV strain) and M. fructigena (VPBG strain) isolated from cherries and plums in Serbia in 2010 [5]. Before the test, both fungi were cultured on Potato Dextrose Agar medium (PDA). The colonies were obtained from 10-day-old culture incubated at 25 °C. To promote sporulation of M. laxa, the strain was sub-cultured on the PDA amended with 1% of acetone [26].
Spore suspensions were obtained by scraping a 15 to 20-day old fungal colony with 5 mL of sterile distilled water (SDW) containing (0.05%) of Tween 20 (v/v) using the tip of a sterile Pasteur pipette. The resulting liquid is filtered using four layers of sterile cheesecloth to remove mycelium fragments and debris after centrifugation. The final conidial concentration was calculated using a hemocytometer and adapted to the desired concentration [16].
2.4. Fruit Preparation
“Golden delicious” apple fruit used in this trial were harvested from an orchard in Imouzzer Kandar, a town in Sefrou Province, Fès-Meknès, Morocco. Only mature and healthy fruits without visible infection or injuries were selected for the in vivo experiment. They were stored at 4 °C at the phytopathology laboratory until use. All fruits were disinfected by soaking in 0.2% (v/v) sodium hypochlorite before being washed three times with SDW. After drying for 1 h, four artificial wounds (4 mm diameter; 3 mm depth) were made on the surface of the fruit [27].
2.5. Antifungal Activity of Essential Oils on Mycelial Growth under In Vitro Conditions
The in vitro test was carried out in Petri dishes (Figure 1). Suspensions of EOs were prepared using (0.05%) Tween 20 as a surfactant to disperse the EOs at different tested concentrations (12.5, 25, 50, and 100 µL/mL). First, 7 µL of the suspension was dropped onto three circular sterilized filter paper (0.5-cm-diameter) pieces, that were then placed in a 9-cm diameter plate containing PDA. The pieces were placed equidistant between the center and plate edge. Next, the 5 mm mycelial disk of each fungus taken from a 7-day-old colony was placed in the center of the plate [28]. After incubation at 25 °C for 7 days, the diameters of the colonies were measured. Four plates were used for each treatment. The experiment was conducted twice over time.
Figure 1.
In vitro dual culture of Monilina laxa with essential oil after 7 days of incubation; (A) PDA medium inoculated only with M. laxa and (B) M. laxa in dual culture with an EO.
2.6. Effect of Essential Oils on Conidial Germination
The germination of conidia of M. laxa and M. fructigena was determined in concentrations of 12.5, 25, 50, and 100 µL/mL of all tested EOs in this study. The method used consisted of mixing the pathogen conidial suspension (1 × 104 spores/mL) of each strain with the EOs at equal volume (1v:1v). The same amount of spore suspension was used without essential oil as the negative control and with methyl-thiophanate fungicide (1 ppm) as the positive control. The mixtures were deposited on sterile micro-centrifuge tubes and incubated at 25 °C. Spore germination was examined under a light microscope after 24 h. At least 100 spores were observed for each replicate at 40× magnification. The data were summarized according to the following formula: GI (%) = [(Gc − Gt)/Gc)] × 100, where GI is germination incidence and Gc and Gt are the mean number of germinated spores in the control and treated tubes, respectively [29]. Each EO concentration covered three replicates twice in time.
2.7. Effect of Essential Oils on Brown Rot Development in Artificially Wounded and Inoculated Fruit
The in vivo test consisted of treating the disinfected and wounded apple fruits with 30 µL of the essential oil suspension at concentrations of 12.5, 25, 50, and 100 µL/mL. After two hours of incubation at room temperature, the treated fruits were inoculated with a conidial aqueous suspension of the two pathogens (20 µL/wound) at a concentration of 1 × 104 spores/mL. Apple fruits treated with SDW and methyl-thiophanate fungicide (1 ppm) served as controls. All fruits were incubated in plastic bags at 20 °C for 10 days with ~95% relative humidity (RH) [16]. Two experiments were performed over time with three replicates for each concentration. Disease severity was measured after 10 days of infection as follows: Disease severity (%) = [(average lesion diameter of treatment/average lesion diameter of control)] × 100. The phytotoxic effect of all EOs on apple fruits was examined during the experiments.
2.8. Efficacy of Essential Oils under Semi-Commercial Conditions
The four EOs that showed the most pronounced antifungal activity, for both the in vitro and vivo conditions, were retained for a semi-commercial large-scale trial. In the same way as the in vivo experiment, washed and disinfected apple fruits were wounded using a needle at 4 equidistant zones (4 mm diameter; 3 mm depth). Apple fruits were sprayed with an EO suspension with different concentrations of 12.5, 25, 50, and 100 µL/mL. The untreated fruits were sprayed only with SDW or a fungicide solution. After 24 h, the treated fruits were sprayed a second time with a spore suspension of M. laxa and M. fructigena at the concentration of 1 ×104 spores/mL. After drying for 2 h at room temperature, apple fruits were placed in plastic bags (5 fruits/bag) and then incubated in darkness at 4 °C. This experiment was repeated twice over time with 5 fruits per repetition for 20 days of incubation [30].
2.9. Quantification of Quality Parameters
2.9.1. Weight Loss
Apple fruit weight loss (WL) was tested with 2 replicates of 5 fruits per treatment. The weight of healthy fruits was registered after 20 days of treatments for the four EO concentrations that showed the highest activity. The mass was measured using a Denver Instrument S-203.3 Summit Series Toploading Balance before treatment (A) and after storage (B). The mass loss was calculated as (A − B)/A [31].
2.9.2. Fruit Firmness and Maturity Index (MI)
The firmness of apple fruits was measured as penetration force (N) using an Agrosta®100 USB Digital Firmness Instrument penetrometer. Values of each fruit were taken at four equidistant points [32]. Furthermore, the maturity index (MI), which is one of the internal quality indicators, was calculated. The MI was determined as the ratio of TSS to TA [32].
2.9.3. Total Soluble Solids
Total soluble solids (TSS) were determined by measuring the refractive index of apple juice diluted 1:1 after 20 days of incubation using a handheld digital refractometer Model PAL-1 (Atago, Tokyo Tech., Tokyo, Japan) and the result was expressed as °Brix [33,34].
2.9.4. Titratable Acidity
Titratable acidity (TA) was measured 20 days after incubation by titration of 10 mL of apple juice diluted with 50 mL of SDW with 0.1 M NaOH to pH 8.1 with phenolphthalein as an indicator using an automatic titrator. TA values were expressed as a percentage of citric acid by the formula: %TA = [(mL NaOH) (N NaOH) (meq.wt.acid)/mL sample] × 100 [34].
2.10. Statistical Analysis
All data were subjected to the analysis of variance (ANOVA) procedure using the statistical software SPSS (version 20). Data presented as percentages were adjusted using the arcsine square root transformation before analysis. Mean separation was performed following Tukey’s test at (p < 0.05). Linear regression equations that relate inhibition of mycelial growth and spore germination to logarithmic EO concentrations were used to determine EC50 concentrations (50% effective concentration).
3. Results
3.1. FT-IR Analysis of the Essential Oils
The FT-IR spectrum was used to determine functional groups of active compounds of the EOs based on the peak level in the infrared radiation area. The most prominent FT-IR peak values and functional groups are reported in Figure 2. For all functional groups, the FT-IR spectra display a general overlap of distinctive absorption peaks [35]. In addition, based on data from the literature, the FT-IR spectral peaks characteristic of the functional groups were identified.

Figure 2.
FT-IR spectra of the nine commercial EOs tested: (EO1) E. radiate; (EO2) L. angustifolia; (EO3) M. pulegium; (EO4) O. compactum; (EO5) R. officinalis; (EO6) T. vulgaris; (EO7) C. sinensis; (EO8) C. aurantium; (EO9) S. aromaticum.
Similarities between most of the spectra were noticed. Many functional groups were identified for all EOs such as carboxylic acids (O-H), alcohols, ether, ester (C-O), anhydrides, alkanes (C-H), alkenes (C=C), and amide (C=O) [36]. The analysis of T. vulgaris EO spectra showed characteristic absorption bands at 3405 cm−1 corresponding to broad O-H stretching in hydration water or phenol and alcohol [37]. For instance, the strong bands at 2954, 2929, and 2878 cm−1 were attributed to asymmetrical and symmetrical C–H stretching vibrations in the functional groups of CH2 and CH3 (aliphatic group) and in aromatic rings (C–H aromatic) as well as the O–CH3 bands in lignins, lipids, saccharides, and esters [38]. The band at 1734 cm−1 was assigned to carbonyl group C=O ester stretching [39]. As expected, the spectra of T. vulgaris EOs showed several bands related to the monoterpenes or aromatic ring vibrations in-plane and out-of-plane bending which were displayed at 1455 and 877 cm−1 [40]. The S. aromaticum EO spectrum revealed absorption vibrations around 3518 cm−1, which can be identified with a hydroxyl group (OH), and several bands in the region between 3077 and 2844 cm−1 that are characteristic of the functional groups CH2 and CH3. Also, a strong band was observed around 1512 cm−1 (eugenol), corresponding to the alkene functional group (C=C). The ether (C-O) functional group was attributed to the region between 1266 and 1232 cm−1. Characteristic absorption bands from 1034 to 746 cm−1 related to the aromatic ring [36,40,41]. The C. sinensis EO displayed characteristic absorption bands at 2919 cm−1 associated with C-H stretch, at 1645 cm−1 for the C=C functional group, and the bands 1436 and 1376 cm−1 were attributed to the bending vibrations of CH3 and CH2 of aliphatic groups. Absorption bands in the range between 866 and 797 cm−1 were characteristic of the =C-H vibration [39,40]. C. aurauntium spectra were defined by several peaks from 2969–2858 cm−1, corresponding to the asymmetric and symmetric stretching vibrations of the –CH3 functional group. The band at 1740 cm−1 was attributed to the C=O stretching vibrations of terpenoid components. Also, stretching bands between 1452 and 1376 cm−1 are assigned to the C-H bending vibrations of alkanes. Vibration bands from 1240 to 919 cm−1 are characteristics of the C-H stretching vibrations of aromatics [42]. The E. radiata EO showed the characteristic peaks at 3000–2855 cm−1, and a group of bands at 1466, 1361, 1215, 1054, and 985 cm−1. The L. angustifolia EO showed absorption within the wavelength region from 3000–2880 cm−1. Other peaks were shown at 3476, 1739, 1374, and 1239 cm−1 and bands in the region of 1239–919 cm−1. The spectra of M. pulegium showed several peaks at 2966–2837 cm−1 and several bands from 1744 to 1678 cm−1 attributed to the monoterpenes, and a band at 890 cm−1 that corresponds to the C-H vibration [41]. For O. compactum, its EO showed absorbance bands at 3414, 2960, 2927, and 2871 cm−1, and several bands at 1621–1117 cm−1. Also, bands at 994, 812, and 640 cm−1 were observed. The spectrum for the EO of R. officinalis was characterized by strong peaks at 3414 cm−1 followed by bands at 2960, 2927, and 2871 cm−1 and vibration bands from 1621 to 812 cm−1.
3.2. Antifungal Activity of Essential Oils on Mycelial Growth under In Vitro Conditions
The evaluation of the EOs of the nine plant species tested for their impact on mycelial growth inhibition of M. laxa and M. fructigena revealed significant antifungal activity (p < 0.05) for all treatments during the 7 days of incubation time (Table 1). In all cases, the methyl-thiophanate fungicide (1 ppm) showed the highest level of inhibition (100%). Results showed that all of the tested EOs had the highest antifungal activity at the 100 µL/mL concentration. However, the potential of T. vulgaris, C. sinensis, C. aurantium, and S. aromaticum EOs for both tested pathogens was higher than the remaining EOs. The effectiveness of S. aromaticum in the reduction of mycelial growth was greater than the other EOs for all concentrations towards the two pathogens. For M. laxa, significant growth inhibition was observed with EOs from S. aromaticum and C. aurantium with 64.02% and 53.72%, respectively, and oregano and eucalyptus EOs displayed an inhibition of 44.64% and 45.14%, respectively, at a concentration of 12.5 µL/mL. For M. fructigena, the lowest mycelial growth inhibition was observed for L. angustifolia (44.92%) and M. pulegium (45.91%). At the concentration of 25 µL/mL, mycelial growth inhibition of M. laxa decreased from 73.05% with clove oil to 49.94% with eucalyptus oil and 49.49% using M. pulegium EO, while L. angustifolia and O. compactum EOs revealed low efficacy for M. fructigena with inhibitions of 51.74% and 51.53%, respectively. Moreover, E. radiata and L. angustifolia EOs showed a low efficacy toward both pathogens at the concentration of 50 µL/mL, with 54.27% and 54.44% for M. laxa, and 56.06% and 56.53% for M. fructigena, respectively. The highest concentration of 100 µL/mL revealed a significant reduction of mycelial growth with 94.69% to M. laxa as well as 94.73% for M. fructigena using S. aromaticum EO. Furthermore, linear regression models were used to calculate EC50 values (Table 2). EC50 values were different from one plant to another, with the highest (least effective) being M. pulegium (21.43 µL/mL), L. angustifolia (21.23 µL/mL), and E. radiata (20.80 µL/mL) compared to the lowest (most effective) EC50 value observed in S. aromaticum (6.74 µL/mL) for M. laxa. Estimated EC50 values for M. fructigena were high for L. angustifolia (21.28 µL/mL) and M. pulegium (18.87 µL/mL) EOs when compared to S. aromaticum (10.09 µL/mL) and C. aurantium (10.36 µL/mL). Overall, our results highlighted that the inhibition efficiency of all tested plants against the mycelial growth for both fungi increased with increasing EO concentrations.

Table 1.
In vitro effect of various essential oil concentrations on mycelial growth of Monilinia laxa and Monilinia fructigena incubated at 25 °C for 7 days.

Table 2.
EC50 values corresponding to 50% inhibition of mycelial growth and spore germination.
3.3. Effect of Essential Oils on Spore Germination
The results reported in Table 2 and Table 3 denote a significant inhibition of spore germination by all the EOs. Spore germination was inhibited at the concentration of 100 (µL/mL) for the S. aromaticum EO for both Monilinia spp. strains and C. sinensis and T. vulgaris against M. laxa and M. fructigena, respectively. Similarly, the methyl-thiophanate fungicide (1 ppm) revealed an inhibition of 100%. At the concentration of 12.5 µL/mL, the highest reduction was achieved by the use of S. aromaticum EOs with 68.5% for M. laxa and 72.5% for M. fructigena, whereas the lowest effect was shown with E. radiata EOs. When tested at 25 µL/mL the EOs of C. aurantium and S. aromaticum inhibited the germination of M. laxa spores by 66.5% and 76.5% while the inhibition values for M. fructigena were 74.5% and 81.5% for the same plants, respectively. In addition, the highest inhibition was obtained using clove, orange, thyme, and neroli EOs at 50 µL/mL after 24 h of incubation for both Monilinia species.

Table 3.
In vitro effect of essential oil concentrations on spore germination of Monilinia laxa and Monilinia fructigena after 24 h of incubation at 25 °C.
The obtained EC50 was different from one essential oil to another. For M. laxa, the highest EC50 values were shown with the E. radiata (73.52 µL/mL), L. angustifolia (63.36 µL/mL), and O. compactum (58.91 µL/mL) plant oils. The lowest (most effective) values were observed with S. aromaticum (7.80 µL/mL). EC50 values for M. fructigena were highest for E. radiata (69.62 µL/mL) and lowest for S. aromaticum (6.00 µL/mL) and C. aurantium (9.99 µL/mL) (Table 2). Our results underlined that plant EOs inhibited spore germination against both fungi strains at the four concentrations used.
3.4. Effect of Essential Oils on Brown Rot Disease Severity
According to the results shown in Table 4, the EOs of T. vulgaris at the concentrations of 12.5 and 25 µL/mL reduced the severity of brown rot to 56.39 and 32.48% for M. laxa and 31.8 and 21.30% for M. fructigena, respectively. However, at 50 µL/mL, clove EOs exhibited a highly significant decrease in severity with values of 8.39% towards M. laxa and 3.44% for M. fructigena, followed by C. sinensis. At 100 µL/mL, all EOs suppressed disease severity in artificially wounded and inoculated fruits with 100% inhibition (0% severity), which was similar to methyl-thiophanate at a concentration of 1 ppm (1 µg/mL).

Table 4.
In vivo effect of essential oils on mycelial growth of Monilinia laxa and Monilinia fructigena incubated at 25 °C for 10 days.
3.5. Semi-Commercial Large-Scale Trial
In a large-scale, semi-commercial study under packing house conditions, the effectiveness of T. vulgaris, C. sinensis, C. aurantium, and S. aromaticum EOs, which demonstrated the least disease severity for both in vitro and in vivo conditions, was evaluated against brown rot. Their performances were compared to the methyl-thiophanate control. According to the analysis of variance, these selected EOs had a significant effect on the development of brown rot caused by M. laxa and M. fructigena (p < 0.05) as illustrated in Table 5. It was found that all treatments significantly reduced the incidence of brown rot with increasing EO concentrations after 20 days of incubation at 4 °C. Apple fruits treated with T. vulgaris, C. aurantium, and S. aromaticum that were inoculated with M. laxa showed 100% rot at the lowest concentration of 12.5 µL/mL; while at the concentration of 100 µL/mL, the incidence was 2.5, 7.5, and 2.5%, respectively for the same EOs compared to 100% incidence of control and 27.5% with methyl-thiophanate. T. vulgaris and C. sinensis showed 100% rot incidence when fruits were inoculated with M. fructigena at 12.5 µL/mL of EO concentration, although at 100 µL/mL, no rot was shown with T. vulgaris EO (0%). Also, a low incidence was obtained with S. aromaticum EOs (27.5%) and C. aurantium EOs (30%) compared to 97.5% for the control and 32.5% with methyl-thiophanate.

Table 5.
Effect of essential oil concentrations on brown rot incidence caused by Monilinia laxa and Monilinia fructigena in apple fruit incubated at 4 °C for 20 days.
3.6. Effect of Treatments on Fruit Quality Parameters
3.6.1. Weight Loss
Results shown in Figure 3A reveal that EO treatments had a significant effect in the reduction of weight loss (%). Generally, all treatments have a lower loss than the control (4.73%) for M. laxa and M. fructigena (4.23%), and were significantly different from one concentration to another. In addition, with the increase of EO concentrations, their efficacy in reducing weight loss increased. For apples inoculated with M. laxa, C. sinensis EO revealed the best reduction of weight loss with 1.98% at 12.5 µL/mL compared to M. fructigena, where the S. aromaticum EO exhibited a significant effect with 1.94% at 12.5 µL/mL.

Figure 3.
Effect of treatments on fruit quality parameters. (A): Weight loss, (B): Firmness, (C): TSS, (D): TA, and (E): Maturity index (MI). In each figure, treatments having the same letters are not significantly different according to Tukey’s test (p < 0.05).
3.6.2. Fruit Firmness
The assessment of fruit firmness indicated that all EOs tested had a positive impact on the preservation of fruit firmness. In addition, the results in Figure 3B highlight a significant effect of fruit firmness. The highest preservative activity was shown with the EOs of C. aurantium for M. laxa at all concentrations, with the lowest value (50.44 N) for 100 µL/mL and the highest value (86 N) at 12.5 µL/mL when compared with the control (73.4 N). Nevertheless, the best result was shown with clove EO for M. fructigena, with a minimal value of 37.57 N at 100 µL/mL and maximal value of 74.03 N at 12.5 µL/mL when compared with the control (75.25 N) (Figure 3B).
3.6.3. Total Soluble Solids
TSS were determined for all treatments (Figure 3C). Generally, values of TSS for apples inoculated with the two fungi declined slightly. Fruits inoculated with M. laxa exhibited a lower TSS value of 9.1 °Brix for the concentration of 12.5 µL/mL when treated with S. aromaticum EO compared with that of the control (15.05 °Brix). Additionally, a lower TSS value for M. fructigena was shown using the same oil concentration with a value of 7.5 °Brix compared to the control (9.95 °Brix) (Figure 3C).
3.6.4. Titratable Acidity
The measurement of the TA level revealed a significant effect of the treatments, whereby TA increased proportionally with increasing EO concentration. Furthermore, at 20 days post-incubation, the TA level in the control fruits was higher than that recorded in the oil-treated fruits (Figure 3D).
3.6.5. Maturity Index
In the case of MI, results showed slight variations of MI between treatments. It was shown that fruits inoculated with Monilinia species and treated with C. aurantium and S. aromaticum EOs had the lowest MI in comparison with other tested oils. Furthermore, the maturity index decreased with an increase in EO concentrations. For 100 µL/mL, the MI of the control was 5.07 compared to methyl-thiophanate with an index of 24.57 for M. laxa. The MI was 3.21 for the control and 18.12 for methyl-thiophanate for fruits inoculated with M. fructigena (Figure 3E).
4. Discussion
Antimicrobials are frequently used to prevent or reduce the growth of spoilage microorganisms in food [43]. Pesticides have several drawbacks, including high costs, risks connected with handling, and residue persistence on food. In addition to these factors, public knowledge of chemical risks has made it critical to create safe and environmentally acceptable pesticide alternatives [29,44]. Plant-derived components, such as EOs, may have a potential for being employed as alternatives to alleviate the difficulties already mentioned. EOs are also biodegradable and have been proven to have a variety of antibacterial characteristics [45,46,47,48]. Furthermore, the antifungal efficacy of twelve commercial EOs, including lavender, spearmint, geranium, basil, and bergamot, was evaluated against Candida albicans strains [49].
The efficacy of nine marketed EOs against two pathogens of apple brown rot was investigated in this study. The effect was concentration-dependent, similar to prior studies [50], with 100 µL/mL showing the best effect for all tested EOs. The encouraging findings in this study suggested that EOs may have important antifungal activity against the brown rot disease agents M. laxa and M. fructigena, and they support the theory that EOs include active components that are responsible for the antifungal activity. The plant species utilized in this study showed promise for the treatment of postharvest infections due to M. laxa and M. fructigena. These findings are in line with those of other investigations that have found significant antifungal activity in a variety of EOs from various plant families [32,51,52,53].
Diverse plant EOs are gaining popularity as new, eco-friendly options for controlling postharvest fungal infections. For example, Neri et al. [54] found that several plant volatiles were extremely effective in inhibiting mycelial development and conidial germination of M. laxa. In vitro tests also revealed that trans-2-hexenal, citral, and carvacrol had a unique effect when compared to the other volatiles examined, and that carvacrol and trans-2-hexenal were the best mycelial growth and germination inhibitors, with MICs of 6.1 and 9.4 L/L, respectively [54].
In vivo treatment with EOs of thyme, savory, and oregano has been demonstrated to be effective against M. laxa on apricots and plums. Furthermore, the in vitro application of Ocimum basilicum var. purpurascens, Ocimum tenuiflorum, R. officinalis, and Thymbra spicata EOs was shown to have significant effects on the mycelial growth of M. laxa or M. fructigena, with inhibition exceeding 100% in the case of R. officinalis (16 µL/Petri dish) and T. spicata (2 µL/Petri dish) [55,56,57]. The same usage of thyme, savory, and oregano EOs on nectarine fruits, on the other hand, was found to be phytotoxic [55]. Several previous studies support the positive effect of T. vulgaris EO that we noticed in our study. For example, even at low concentrations, it has a significant impact against brown rot on nectarines and peaches [58]. The high efficacy of T. vulgaris against Macrophomina phaseolina, Drechslera spicifera, and Fusarium oxysporum f.sp. ciceris may be due to its unique chemical composition, which is rich in oxygenated monoterpenes: thymol (36.81%) and cymene (30.90%) [59]. Furthermore, our findings are consistent with those of Fathi et al. [60], who found that T. vulgaris EO inhibited M. fructicola and Botrytis cinerea growth completely at concentrations of more than 400 µL/L.
We found that at a dosage of 100 µL/mL, S. aromaticum EO reduced the growth of both pathogens in our study. These findings are comparable to those of Sameza et al. [61], who found that at doses of 200 and 300 ppm, Rhizopus stolonifer and Fusarium solani mycelial growth were completely inhibited. As a result, they identified this EO as a potent source of antifungal compounds, with eugenol as the primary component (79.4%). Other researchers observed comparable results after treating M. laxa, M. fructigena, B. cinerea, Penicillium expansum, and Phlyctema laxa with clove bud EO (2.0 mL/L) or eugenol solution (1 mg/mL) [62,63]. The findings of Wang et al. [64] substantially supported the notion that eugenol’s antifungal activity is due to permeability changes after membrane binding, which causes the pathogen’s membrane to be disrupted and destabilized. From the data shown above, we can see that both citrus EOs have significant mycelial growth inhibition against the two species of Monilinia. However, little is known regarding the effects of C. aurantium and C. sinensis on brown rot induced by M. laxa and M. fructigena at this time. The presence of limonene as a significant constituent, with a percentage of 87.02%, was observed in some research studying the chemical composition and antifungal activity of the two citrus species EOs. Furthermore, at various concentrations, these EOs showed significant antifungal effects against a variety of fungal species, including Penicillium italicum [65], Geotrichum citri-aurantii [66], and, more recently, Penicillium expansum, Penicillium citrinum, and Penicillium crustosum [67]. Other research has demonstrated that the antimicrobial activity of C. aurantium EO is dependent on specific microbial species, but that the activity is strain-dependent, which is comparable with our findings [68]. The present investigation found that C. sinensis EO significantly inhibited both Monilinia species, with a proportion greater than 90%. Additional studies have found that C. sinensis EO [69], other C. sinensis kinds EOs (Bahia navel orange and lima orange) [70], and commercial C. sinensis EOs have a good antifungal potential against a variety of infections [71]. Essential oils from other citrus species, on the other hand, have been found to suppress fungal infections of grapevine wood [72].
All of the EOs tested against the two fungi significantly inhibited spore germination according to the results of this investigation. The best results were achieved with four EOs that had previously demonstrated effective in vitro activity. Additionally, T. vulgaris, S. aromaticum, C. arauntium, and C. sinensis showed a 95% suppression of M. laxa and M. fructigena. These findings are consistent with those of Fathi et al. [60], who observed 100% spore germination suppression of B. cinerea using T. vulgaris EO at 600 µL/L. A comparable investigation found that using T. vulgaris commercial EO at a concentration of 1000 µL/L resulted in a spore germination inhibition of 98% [73]. Sameza et al. [61] reported on the significant effect of S. aromaticum essential oil in inhibiting spore germination of F. solani (MIC = 250 ppm) and R. stolonifer (MIC = 31.25 ppm). Similarly, Trabelsi et al. [65] reported that using 50 mg/mL of neroli EO (C. aurauntium) reduced spore germination by 25% for P. digitatum and 22.5% for P. italicum. The effect of the C. sinensis EO on B. cinerea, Alternaria alternata, Fusarium solani, and Fusarium oxysporum was studied by Badawy et Abdelgaleil [74]. When compared to the control, all of the fungi showed a significant reduction in spore germination. A. alternata (EC50 = 268 mg/L) and F. oxysporum (EC50 = 166 mg/L) were also inhibited by the EO. Another study examined the effects of citrus essential oil (bergamot EO) on A. alternata, Penicillium chrysogenum, and A. niger [75]. A significant reduction in spore germination was realized. Sharma and Prakash [76] also evaluated C. sinensis EO against a variety of postharvest diseases. They showed that at 500 ppm, this oil had a significant inhibitory effect on A. niger spore germination, and that, in comparison to the control, the spores that germinated at low concentrations produced little germ tubes.
In the in vivo study, the four EOs chosen from the in vitro trials inhibited both Monilinia species in artificially damaged and inoculated fruit. EOs had no phytotoxic effect on the tissues of the fruit at any of the levels examined. Furthermore, under semi-commercial conditions for apple fruits, these EOs proved their efficacy against M. laxa and M. fructigena and considerably reduced the incidence of brown rot. There is currently limited research on the in vivo effect of EOs, particularly citrus EOs, on brown rot. Elshafie et al. [77] evaluated the in vivo antifungal efficacy of T. vulgaris against brown rot caused by M. fructicola and M. laxa, and found that T. vulgaris EO treatment at 500 ppm reduced brown rot lesion significantly. Our findings revealed that T. vulgaris has a significant impact on apple fruit brown rot, which is similar to the findings of other researchers who examined T. vulgaris’ in vivo effects on B. cinerea and P. expansum for several apple cultivars. After 15 days of storage, results showed that thyme EO at 10% was statistically beneficial against P. expansum, and treatments with 1% and 10% of the EO were statistically similar to the chemical control for B. cinerea [55]. Gebel and Magurno [78] investigated the in vivo antifungal activity of T. vulgaris essential oil at two concentrations: 200 µL/mL and 500 µL/mL. They demonstrated a high efficacy of thyme EO in reducing gray mold incidence and found that a 500 µL/mL dose effectively inhibited B. cinerea mycelial growth after 7 days. Vitoratos et al. [79] investigated the effect of thyme EO on B. cinerea growth in vivo. They showed that thyme essential oil was only marginally effective on strawberries, tomatoes, and cucumbers that had been artificially inoculated.
Many biobased products have been reported to control and reduce the prevalence of postharvest diseases. Eugenol-based formulations (eugenol at 2 mg/mL mixed with lecithin at 50 mg/mL) were tested on M. fructigena among these biobased products. After 6 months of cold storage at 2 °C, a significant reduction in disease incidence was reported, with values ranging from 60 to 100% [64]. Another study looked into the in vivo biocontrol of Colletotrichum gloeosporioides using S. aromaticum EO. Fruits treated with a concentration of 50 g/l of the EO had the lowest infection [80].
Our research found that EOs had a significant impact on the control of brown rot disease. In line with earlier findings, an in vivo study of neroli oil (C. aurauntium) against Penicillium spp. Was found to have potent antifungal activity, reducing disease incidence by 36% following storage [65].
Aside from the effectiveness against postharvest brown rot, fruit quality parameters were examined during a 20-day storage period at 4 °C. T. vulgaris, S. aromaticum, C. sinensis, and C. aurauntium were used to preserve the quality attributes examined here, including WL, TSS, TA, firmness, and MI. Our findings are in line with those of Santoro et al. [58], who found that thyme EO improved the quality of peaches and nectarines by lowering WL and preserving the ascorbic acid and carotenoid content. Hassani et al. [32] also established the efficacy of thyme and eugenol EOs against M. fructicola and B. cinerea, as well as their sensory effects. The results showed that EO treatments reduced WL significantly and that their impact was dose-dependent. Furthermore, both EOs had the strongest preservation effects on fruit firmness at a concentration of 400 µL/L. For TSS, it was reported that the TSS level was negatively connected with concentration in fruits inoculated with B. cinerea, however, the TSS level was more important at 600 µL/L in fruits inoculated with M. fructicola. In addition, as the concentration of EOs grew, TA increased. When it came to MI, it was found that fruits infected with both species had a low MI. Our results supported the findings of Abdolahi et al. [81], who found that treated fruits had lower WL, TSS, and TA than control table grapes treated with thyme oil. On the other hand, Ranasinghe et al. [82] hypothesized that treating banana fruits with S. aromaticum EO as a biopesticide for the suppression of postharvest infections would alter the fruit’s sensory quality in some situations. Similarly, Azarakhsh et al. [83] found that adding 0.5% lemongrass essential oils to alginate-based edible coatings reduced the sensory quality of freshly cut pineapple fruit. Similarly, applying an apple puree alginate coating with the same EO reduced the sensory features of apple fruits, particularly the texture [84]. T. vulgaris, S. aromaticum, C. sinensis, and C. aurauntium EOs had a substantial effect on WL, fruit firmness, TSS, TA, and MI when applied to apple fruits. Although the mechanisms of this action have not been elucidated, it is obvious from our findings that the usage of EOs influences the biochemical alterations of the fruit.
FT-IR spectroscopy uses infrared light to irradiate the sample and the absorbed energy to produce a specific spectrum dependent on the chemical composition of the sample. The findings of this investigation revealed that EOs have potent antifungal properties, which can be attributed to the presence of a variety of chemical components, including monoterpenoids. The T. vulgaris EO spectrum exhibited important bands belonging to monoterpene composites, which may be one of the key chemicals that affect the biological activity of Monilinia spp. according to various studies on the chemical composition of EOs. Thymol and carvacrol are the main components of thyme EO [37]. Furthermore, the strong band identified in the spectra of S. aromaticum EO at 1512 cm−1 was found to belong to either eugenol or eugenol acetate, according to research conducted by Rodriguez et al. in 2018 [41]. The EOs of the two citrus species investigated were distinguished by many bands containing diverse volatile constituents. The chemical composition of citrus EO was examined by Boughendjioua and Djeddi [39], who found that limonene was the most important component (61.64%). This finding is consistent with another study [85] that revealed the chemical composition of orange oil, with limonene as the predominant component (87.52%). According to authors who analyzed the FT-IR of Mentha specata EO [86], the strong band seen on the M. pulegium spectra can be linked to one of the principal chemicals present in the EO, (R)-carvone, which displayed peaks in the region of 1680–1676 cm−1.
The absorption signals for several wavenumber ranges were found in the FT-IR spectrum of all tested EOs, confirming that the major functional groups of the components contained in the EOs studied are present, including alcohol and phenols (O–H), methyl and aldehyde functional groups (stretching of C–H bonds), amines and amides (N–H bending), and aromatics (C–C stretching) [87].
5. Conclusions
In conclusion, the results obtained through in vitro spore germination, in vivo fruit quality parameters, and FT-IR characterization highlighted that most examined EOs can be used to inhibit or reduce infections produced by M. laxa, and M. fructigena with small differences between both fungi at any concentration. Therefore, their antifungal potential can be attributed to the presence of volatile constituents and the synergy between the major and minor components, or due to the pathogen’s mechanism of resistance to specific compounds found in EOs. Moreover, it is shown that T. vulgaris, S. aromaticum, C. sinensis, and C. aurauntium EOs could effectively control brown rot and seem to be a promising alternative to fungicides. As we know, the commercialization of EOs is still restricted because of their low permeability, low solubility, and uncontrolled volatility. For this purpose, the most effective strategy to avoid these limitations is to develop proper formulations by encapsulation of EOs in nanoemulsions, which is one of our perspectives.
Author Contributions
Conceptualization, A.E.K. and R.L.; methodology, A.E.K. and R.L.; software, A.E.K. and S.E.; validation, A.E.K., R.L., O.M. and L.E.G.; formal analysis, A.E.K., R.L. and S.E.; investigation, R.L.; resources, R.L. and A.T.; data curation, A.E.K., L.A.H. and S.E.; writing—original draft preparation, A.E.K., R.L. and S.E.; writing—review and editing, A.E.K., R.L., Z.B., O.M. and S.E.; visualization, R.L.; supervision, R.L. and L.E.G.; project administration, R.L.; funding acquisition, R.L. and O.M. All authors have read and agreed to the published version of the manuscript.
Funding
This research received no external funding.
Institutional Review Board Statement
Not applicable.
Informed Consent Statement
Not applicable.
Data Availability Statement
The data used for the analyses in this study are available within the article, while the datasets used or analyzed during the current study are available from the corresponding author upon reasonable request.
Acknowledgments
This research was financially supported by the Department of Plant Protection, Phytopathology Unit, Ecole Nationale d’Agriculture de Meknes. The authors thank the Laboratoire Central de Recherche (LCR, ENA-Meknès) for making the FT-IR instrument available at their disposal.
Conflicts of Interest
The authors declare no conflict of interest.
References
- Cornille, A.; Giraud, T.; Smulders, M.J.M.; Roldán-Ruiz, I.; Gladieux, P. The domestication and evolutionary ecology of apples. Trends Genet. 2014, 30, 57–65. [Google Scholar] [CrossRef] [PubMed]
- Moinina, A.; Lahlali, R.; Boulif, M. Important pests, diseases and weather conditions affecting apple production in Morocco: Current state and perspectives. Rev. Maroc. Des Sci. Agron. Vét. 2019, 7, 71–87. [Google Scholar]
- Barkai-Golan, R. Postharvest Diseases of Fruits and Vegetables: Development and Control; Elsevier: Amsterdam, The Netherlands, 2001; ISBN 0080539297. [Google Scholar]
- Nabila, E.A.; Soufiyan, E.A. Use of Plant Extracts in the Control of Post-Harvest Fungal Rots in Apples. J. Bot. Res. 2019, 2, 31–58. [Google Scholar] [CrossRef]
- Hrustić, J.; Delibašić, G.; Stanković, I.; Grahovac, M.; Krstić, B.; Bulajić, A.; Tanović, B. Monilinia spp. causing brown rot of stone fruit in Serbia. Plant Dis. 2015, 99, 709–717. [Google Scholar] [CrossRef] [PubMed]
- Di Francesco, A.; Martini, C.; Mari, M. Biological control of postharvest diseases by microbial antagonists: How many mechanisms of action? Eur. J. Plant Pathol. 2016, 145, 711–717. [Google Scholar] [CrossRef]
- Rungjindamai, N.; Jeffries, P.; Xu, X.-M. Epidemiology and management of brown rot on stone fruit caused by Monilinia laxa. Eur. J. Plant Pathol. 2014, 140, 1–17. [Google Scholar] [CrossRef]
- Holb, I.J. Brown rot blossom blight of pome and stone fruits: Symptom, disease cycle, host resistance, and biological control. Int. J. Hortic. Sci. 2008, 14, 15–21. [Google Scholar] [CrossRef]
- Hrustić, J.; Mihajlović, M.; Grahovac, M.; Delibašić, G.; Bulajić, A.; Krstić, B.; Tanović, B. Genus Monilinia on pome and stone fruit species. Pestic. Fitomedicina 2012, 27, 283–297. [Google Scholar] [CrossRef]
- Martini, C.; Mari, M. Monilinia fructicola, Monilinia laxa (Monilinia rot, brown rot). In Postharvest Decay; Elsevier: Amsterdam, The Netherlands, 2014; pp. 233–265. [Google Scholar]
- Egüen, B.; Melgarejo, P.; De Cal, A. The effect of fungicide resistance on the structure of Monilinia laxa populations in Spanish peach and nectarine orchards. Eur. J. Plant Pathol. 2016, 145, 815–827. [Google Scholar] [CrossRef]
- Talibi, I.; Boubaker, H.; Boudyach, E.H.; Ait Ben Aoumar, A. Alternative methods for the control of postharvest citrus diseases. J. Appl. Microbiol. 2014, 117, 1–17. [Google Scholar] [CrossRef]
- Moraes Bazioli, J.; Belinato, J.R.; Costa, J.H.; Akiyama, D.Y.; Pontes, J.G.d.M.; Kupper, K.C.; Augusto, F.; de Carvalho, J.E.; Fill, T.P. Biological Control of Citrus Postharvest Phytopathogens. Toxins 2019, 11, 460. [Google Scholar] [CrossRef] [PubMed]
- Askarne, L.; Talibi, I.; Boubaker, H.; Boudyach, E.H.; Msanda, F.; Saadi, B.; Serghini, M.A.; Ait Ben Aoumar, A. In vitro and in vivo antifungal activity of several Moroccan plants against Penicillium italicum, the causal agent of citrus blue mold. Crop Prot. 2012, 40, 53–58. [Google Scholar] [CrossRef]
- González-Domínguez, E.; Armengol, J.; Rossi, V. Biology and epidemiology of Venturia species affecting fruit crops: A review. Front. Plant Sci. 2017, 8, 1496. [Google Scholar] [CrossRef] [PubMed]
- Elkhetabi, A.; Lahlali, R.; Askarne, L.; Ezrari, S.; El Ghadaroui, L.; Tahiri, A.; Hrustić, J.; Amiri, S. Efficacy assessment of pomegranate peel aqueous extract for brown rot (Monilinia spp.) disease control. Physiol. Mol. Plant Pathol. 2020, 110, 101482. [Google Scholar] [CrossRef]
- Jijakli, M.H.; Lepoivre, P. State of the art and challenges of post-harvest disease management in apples. In Fruit and Vegetable Diseases; Springer: Berlin/Heidelberg, Germany, 2004; pp. 59–94. [Google Scholar]
- Raveau, R.; Fontaine, J.; Lounès-Hadj Sahraoui, A. Essential oils as potential alternative biocontrol products against plant pathogens and weeds: A review. Foods 2020, 9, 365. [Google Scholar] [CrossRef]
- Bakkali, F.; Averbeck, S.; Averbeck, D.; Idaomar, M. Biological effects of essential oils—A review. Food Chem. Toxicol. 2008, 46, 446–475. [Google Scholar] [CrossRef]
- Turek, C.; Stintzing, F.C. Stability of essential oils: A review. Compr. Rev. Food Sci. Food Saf. 2013, 12, 40–53. [Google Scholar] [CrossRef]
- Pontes, E.K.U.; Melo, H.M.; Nogueira, J.W.A.; Firmino, N.C.S.; de Carvalho, M.G.; Júnior, F.E.A.C.; Cavalcante, T.T.A. Antibiofilm activity of the essential oil of citronella (Cymbopogon nardus) and its major component, geraniol, on the bacterial biofilms of Staphylococcus aureus. Food Sci. Biotechnol. 2019, 28, 633–639. [Google Scholar] [CrossRef]
- El-Kalamouni, C.; Venskutonis, P.R.; Zebib, B.; Merah, O.; Raynaud, C.; Talou, T. Antioxidant and antimicrobial activities of the essential oil of Achillea millefolium L. grown in France. Medicines 2017, 4, 30. [Google Scholar] [CrossRef]
- Sayed-Ahmad, B.; Talou, T.; Saad, Z.; Hijazi, A.; Cerny, M.; Kanaan, H.; Chokr, A.; Merah, O. Fennel oil and by-products seed characterization and their potential applications. Ind. Crops Prod. 2018, 111, 92–98. [Google Scholar] [CrossRef]
- Merah, O.; Sayed-Ahmad, B.; Talou, T.; Saad, Z.; Cerny, M.; Grivot, S.; Evon, P.; Hijazi, A. Biochemical composition of cumin seeds, and biorefining study. Biomolecules 2020, 10, 1054. [Google Scholar] [CrossRef] [PubMed]
- Hrustić, J.; Mihajlović, M.; Grahovac, M.; Delibašić, G.; Tanović, B. Fungicide sensitivity, growth rate, aggressiveness and frost hardiness of Monilinia fructicola and Monilinia laxa isolates. Eur. J. Plant Pathol. 2018, 151, 389–400. [Google Scholar] [CrossRef]
- Pascual, S. Induction of Conidia Production by Monilinia laxa on Agar Media by Acetone. Phytopathology 1990, 80, 494. [Google Scholar] [CrossRef]
- Talibi, I.; Karim, H.; Askarne, L.; Boubaker, H.; Boudyach, E.H.; Msanda, F.; Saadi, B.; Ait Ben Aoumar, A. Antifungal activity of aqueous and organic extracts of eight aromatic and medicinal plants against Geotrichum candidum, causal agent of citrus sour rot. Int. J. Agron. Plant Prod. 2013, 4, 3510–3521. [Google Scholar]
- Liu, Y.; Chen, Z.; Liu, Y.; Wang, X.; Luo, C.; Nie, Y.; Wang, K. Enhancing bioefficacy of Bacillus subtilis with sodium bicarbonate for the control of ring rot in pear during storage. Biol. Control 2011, 57, 110–117. [Google Scholar] [CrossRef]
- Soylu, E.M.; Kurt, Ş.; Soylu, S. In vitro and in vivo antifungal activities of the essential oils of various plants against tomato grey mould disease agent Botrytis cinerea. Int. J. Food Microbiol. 2010, 143, 183–189. [Google Scholar] [CrossRef] [PubMed]
- Lahlali, R.; Aksissou, W.; Lyousfi, N.; Ezrari, S.; Blenzar, A.; Tahiri, A.; Ennahli, S.; Hrustić, J.; MacLean, D.; Amiri, S. Biocontrol activity and putative mechanism of Bacillus amyloliquefaciens (SF14 and SP10), Alcaligenes faecalis ACBC1, and Pantoea agglomerans ACBP1 against brown rot disease of fruit. Microb. Pathog. 2020, 139, 103914. [Google Scholar] [CrossRef]
- Sangwanich, S.; Sangchote, S.; Leelasuphakul, W. Biocontrol of citrus green mould and postharvest quality parameters. Int. Food Res. J. 2013, 20, 3381. [Google Scholar]
- Hassani, A.; Fathi, Z.; Ghosta, Y.; Abdollahi, A.; Meshkatalsadat, M.H.; Marandi, R.J. Evaluation of plant essential oils for control of postharvest brown and gray mold rots on apricot. J. Food Saf. 2012, 32, 94–101. [Google Scholar] [CrossRef]
- Qin, X.; Xiao, H.; Xue, C.; Yu, Z.; Yang, R.; Cai, Z.; Si, L. Biocontrol of gray mold in grapes with the yeast Hanseniaspora uvarum alone and in combination with salicylic acid or sodium bicarbonate. Postharvest Biol. Technol. 2015, 100, 160–167. [Google Scholar] [CrossRef]
- Pobiega, K.; Igielska, M.; Włodarczyk, P.; Gniewosz, M. The use of pullulan coatings with propolis extract to extend the shelf life of blueberry (Vaccinium corymbosum) fruit. Int. J. Food Sci. Technol. 2021, 56, 1013–1020. [Google Scholar] [CrossRef]
- Li, Y.; Kong, D.; Lin, X.; Xie, Z.; Bai, M.; Huang, S.; Nian, H.; Wu, H. Quality evaluation for essential oil of Cinnamomum verum leaves at different growth stages based on GC–MS, FTIR and microscopy. Food Anal. Methods 2016, 9, 202–212. [Google Scholar] [CrossRef]
- Das, A.; Dhinesh Kannan, S.K.; Harshadha, K.; Hari Raj, K.; Bindhu, J. Molecular characterization and evaluation of antimicrobial activity of essential oils derived from Syzygium aromaticum. Int. J. Green Pharm. 2018, 12, 56–61. [Google Scholar]
- Catauro, M.; Bollino, F.; Tranquillo, E.; Sapio, L.; Illiano, M.; Caiafa, I.; Naviglio, S. Chemical analysis and anti-proliferative activity of Campania Thymus Vulgaris essential oil. J. Essent. Oil Res. 2017, 29, 461–470. [Google Scholar] [CrossRef]
- Ostolski, M.; Adamczak, M.; Brzozowski, B.; Stolarski, M.J. Screening of functional compounds in supercritical carbon dioxide extracts from perennial herbaceous crops. Agriculture 2021, 11, 488. [Google Scholar] [CrossRef]
- Boughendjioua, H. Fourier Transformed Infrared Spectroscopy Analysis of Constituents of Lemon Essential Oils from Algeria. Am. J. Opt. Photonics 2017, 5, 30. [Google Scholar] [CrossRef]
- Bounaas, K.; Bouzidi, N.; Daghbouche, Y.; Garrigues, S.; de la Guardia, M.; Hattab, M. El Essential oil counterfeit identification through middle infrared spectroscopy K. Microchem. J. 2018, 139, 347–356. [Google Scholar] [CrossRef]
- Rodríguez, J.W.; Peyron, S.; Rigou, P.; Chalier, P. Rapid quantification of clove (Syzygium aromaticum) and spearmint (Mentha spicata) essential oils encapsulated in a complex organic matrix using an ATR-FTIR spectroscopic method. PLoS ONE 2018, 13, 1–17. [Google Scholar] [CrossRef] [PubMed]
- Cebi, N.; Taylan, O.; Abusurrah, M.; Sagdic, O. Detection of Orange Essential Oil, Isopropyl Myristate, and Benzyl Alcohol in Lemon Essential Oil by FTIR Spectroscopy Combined with Chemometrics. Foods 2020, 10, 27. [Google Scholar] [CrossRef] [PubMed]
- Pateiro, M.; Munekata, P.E.S.; Sant’Ana, A.S.; Domínguez, R.; Rodríguez-Lázaro, D.; Lorenzo, J.M. Application of essential oils as antimicrobial agents against spoilage and pathogenic microorganisms in meat products. Int. J. Food Microbiol. 2021, 337, 108966. [Google Scholar] [CrossRef] [PubMed]
- Koum, O.; Walla, S.; DhaliwalL, G.S. Essential Oils as Green Pesticides: Potential and Constraints. Biopestic. Int. 2008, 4, 63–84. [Google Scholar] [CrossRef][Green Version]
- Isman, M.B. Plant essential oils for pest and disease management. Crop Prot. 2000, 19, 603–608. [Google Scholar] [CrossRef]
- Basaid, K.; Chebli, B.; Mayad, E.H.; Furze, J.N.; Krier, F.; Barakate, M.; Paulitz, T.; Basaid, K.; Chebli, B.; Mayad, E.H.; et al. Biological activities of essential oils and lipopeptides applied to control plant pests and diseases: A review. Int. J. Pest Manag. 2020, 67, 1–23. [Google Scholar] [CrossRef]
- Reddy, S.G.E.; Dolma, S.K. Acaricidal activities of essential oils against two-spotted spider mite, Tetranychus urticae Koch. Toxin Rev. 2018, 37, 62–66. [Google Scholar] [CrossRef]
- Korona-Glowniak, I.; Glowniak-Lipa, A.; Ludwiczuk, A.; Baj, T.; Malm, A. The in vitro activity of essential oils against Helicobacter pylori growth and urease activity. Molecules 2020, 25, 586. [Google Scholar] [CrossRef]
- Serra, E.; Hidalgo-Bastida, L.A.; Verran, J.; Williams, D.; Malic, S. Antifungal activity of commercial essential oils and biocides against Candida albicans. Pathogens 2018, 7, 15. [Google Scholar] [CrossRef]
- Palfi, M.; Konjevoda, P.; Vrandečić, K. Antifungal activity of essential oils on mycelial growth of Fusarium oxysporum and Bortytis cinerea. Emir. J. Food Agric. 2019, 31, 544–554. [Google Scholar] [CrossRef]
- Tzortzakis, N.G. Impact of cinnamon oil-enrichment on microbial spoilage of fresh produce. Innov. Food Sci. Emerg. Technol. 2009, 10, 97–102. [Google Scholar] [CrossRef]
- Lawson, S.K.; Sharp, L.G.; Powers, C.N.; McFeeters, R.L.; Satyal, P.; Setzer, W.N. Volatile compositions and antifungal activities of native american medicinal plants: Focus on the asteraceae. Plants 2020, 9, 126. [Google Scholar] [CrossRef]
- Rezgui, M.; Majdoub, N.; Mabrouk, B.; Baldisserotto, A.; Bino, A.; Ben Kaab, L.B.; Manfredini, S. Antioxidant and antifungal activities of marrubiin, extracts and essential oil from Marrubium vulgare L. against pathogenic dermatophyte strains. J. Mycol. Med. 2020, 30, 100927. [Google Scholar] [CrossRef]
- Neri, F.; Mari, M.; Brigati, S.; Bertolini, P. Fungicidal activity of plant volatile compounds for controlling Monilinia laxa in stone fruit. Plant Dis. 2007, 91, 30–35. [Google Scholar] [CrossRef]
- Lopez-Reyes, J.G.; Spadaro, D.; Prelle, A.; Garibaldi, A.; Gullino, M.L. Efficacy of plant essential oils on postharvest control of rots caused by fungi on different stone fruits in vivo. J. Food Prot. 2013, 76, 631–639. [Google Scholar] [CrossRef]
- Carovic-Stanko, K.; Fruk, G.; Satovic, Z.; Ivic, D.; Politeo, O.; Sever, Z.; Grdiša, M.; Strikic, F.; Jemric, T. Effects of Ocimum spp. essential oil on Monilinia laxa in vitro. J. Essent. Oil Res. 2013, 25, 143–148. [Google Scholar] [CrossRef]
- Yılar, M.; Bayan, Y. Antifungal Activity of Thymbra spicata L. and Rosmarinus officinalis L. Essential Oils against Monilinia fructigena Honey in Whetze. Türk Tarım Doğa Bilim. Derg. 2018, 5, 121–126. [Google Scholar] [CrossRef][Green Version]
- Santoro, K.; Maghenzani, M.; Chiabrando, V.; Bosio, P.; Gullino, M.L.; Spadaro, D.; Giacalone, G. Thyme and savory essential oil vapor treatments control brown rot and improve the storage quality of peaches and nectarines, but could favor gray mold. Foods 2018, 7, 7. [Google Scholar] [CrossRef] [PubMed]
- Moghaddam, M.; Mehdizadeh, L. Chemical Composition and Antifungal Activity of Essential Oil of Thymus vulgaris Grown in Iran against Some Plant Pathogenic Fungi. J. Essent. Oil-Bear. Plants 2020, 23, 1072–1083. [Google Scholar] [CrossRef]
- Fathi, Z.; Hassani, A.; Ghosta, Y.; Abdollahi, A.; Meshkatalsadat, M.H. The potential of thyme, clove, cinnamon and ajowan essential oils in inhibiting the growth of Botrytis cinerea and Monilinia fructicola. J. Essent. Oil-Bear. Plants 2012, 15, 38–47. [Google Scholar] [CrossRef]
- Sameza, M.L.; Nguemnang Mabou, L.C.; Tchameni, S.N.; Boat Bedine, M.A.; Tchoumbougnang, F.; Jazet Dongmo, P.M.; Boyom Fekam, F. Evaluation of clove essential oil as a mycobiocide against Rhizopus stolonifer and Fusarium solani, tuber rot causing fungi in yam (Dioscorea rotundata Poir.). J. Phytopathol. 2016, 164, 433–440. [Google Scholar] [CrossRef]
- Hashem, M.; Alamri, S.A.M.; Alqahtani, M.S.A.; Alshehri, S.R.Z. A multiple volatile oil blend prolongs the shelf life of peach fruit and suppresses postharvest spoilage. Sci. Hortic. 2019, 251, 48–58. [Google Scholar] [CrossRef]
- Amiri, A.; Dugas, R.; Pichot, A.L.; Bompeix, G. In vitro and in vivo activity of eugenol oil (Eugenia caryophylata) against four important postharvest apple pathogens. Int. J. Food Microbiol. 2008, 126, 13–19. [Google Scholar] [CrossRef] [PubMed]
- Wang, C.; Zhang, J.; Chen, H.; Fan, Y.; Shi, Z. Antifungal activity of eugenol against Botrytis cinerea. Trop. Plant Pathol. 2010, 35, 137–143. [Google Scholar] [CrossRef]
- Trabelsi, D.; Hamdane, A.M.; Ben Said, M.; Abdrrabba, M. Chemical Composition and Antifungal Activity of Essential Oils from Flowers, Leaves and Peels of Tunisian Citrus aurantium Against Penicillium digitatum and Penicillium italicum. J. Essent. Oil-Bear. Plants 2016, 19, 1660–1674. [Google Scholar] [CrossRef]
- Regnier, T.; Combrinck, S.; Veldman, W.; Du Plooy, W. Application of essential oils as multi-target fungicides for the control of Geotrichum citri-aurantii and other postharvest pathogens of citrus. Ind. Crops Prod. 2014, 61, 151–159. [Google Scholar] [CrossRef]
- Kačániová, M.; Terentjeva, M.; Galovičová, L.; Ivanišová, E.; Štefániková, J.; Valková, V.; Borotová, P.; Kowalczewski, P.Ł.; Kunová, S.; Felšöciová, S. Biological activity and antibiofilm molecular profile of Citrus aurantium essential oil and its application in a food model. Molecules 2020, 25, 3956. [Google Scholar] [CrossRef]
- Casquete, R.; Castro, S.M.; Martín, A.; Ruiz-Moyano, S.; Saraiva, J.A.; Córdoba, M.G.; Teixeira, P. Evaluation of the effect of high pressure on total phenolic content, antioxidant and antimicrobial activity of citrus peels. Innov. Food Sci. Emerg. Technol. 2015, 31, 37–44. [Google Scholar] [CrossRef]
- Viuda, M.; Ruiz, Y.; Fernandez-Lopez, J.; Perez, A. Antifungal activity of lemon (Citrus lemon L.), mandarin (C. reticulata L.), grapefruit (C. paridisi L) and orange (C. sinensis) vs. essential oils. Food Saf. 2008, 28, 567–576. [Google Scholar] [CrossRef]
- Rezende, J.L.; Fernandes, C.C.; Costa, A.O.M.; Santos, L.S.; Vicente, F.; Sperandio, E.M.; Souchie, E.L.; Colli, A.C.; Crotti, A.E.M.; Miranda, M.L.D. Antifungal potential of essential oils from two varieties of Citrus sinensis (lima orange and bahia navel orange) in postharvest control of Rhizopus stolonifer (Ehrenb.: Fr.) Vuill. Food Sci. Technol. 2020, 40, 405–409. [Google Scholar] [CrossRef]
- De Clerck, C.; Maso, S.D.; Parisi, O.; Dresen, F.; Zhiri, A.; Haissam Jijakli, M. Screening of antifungal and antibacterial activity of 90 commercial essential oils against 10 pathogens of agronomical importance. Foods 2020, 9, 1418. [Google Scholar] [CrossRef]
- Ammad, F.; Moumen, O.; Gasem, A.; Othmane, S.; Hisashi, K.-N.; Zebib, B.; Merah, O. The potency of lemon (Citrus limon L.) essential oil to control some fungal diseases of grapevine wood. C. R. Biol. 2018, 341, 97–101. [Google Scholar] [CrossRef]
- Lazar-Baker, E.E.; Hetherington, S.D.; Ku, V.V.; Newman, S.M. Evaluation of commercial essential oil samples on the growth of postharvest pathogen Monilinia fructicola (G. Winter) Honey. Lett. Appl. Microbiol. 2011, 52, 227–232. [Google Scholar] [CrossRef]
- Badaway, M.E.I.; Abdelgaleil, S.A.M. Composition and antimicrobial activity of essential oils isolated from Egyptian plants against plan pathogenic bacteria and fungi. Ind. Crops Prod. 2014, 52, 776–782. [Google Scholar] [CrossRef]
- Phillips, C.A.; Laird, K.; Allen, S.C. The use of Citri-VTM®—An antimicrobial citrus essential oil vapour for the control of Penicillium chrysogenum, Aspergillus niger and Alternaria alternata in vitro and on food. Food Res. Int. 2012, 47, 310–314. [Google Scholar] [CrossRef]
- Sharma, N.; Prakash, S.M. Integrated management of soybean (Glycine× max L. Merr.) By essential oil of Citrus× sinensis L. cv. ’osbeck’ epicarp in postharvest. JOP 2012, 2, 33–44. [Google Scholar]
- Elshafie, H.S.; Mancini, E.; Camele, I.; De Martino, L.; De Feo, V. In vivo antifungal activity of two essential oils from Mediterranean plants against postharvest brown rot disease of peach fruit. Ind. Crops Prod. 2015, 66, 11–15. [Google Scholar] [CrossRef]
- Gebel, M.P.; Magurno, F. Assessment of the antifungal potential of the essential oil from Thymus vulgaris against Botrytis cinerea causative agent of postharvest grey mould on strawberry fruits. Columella J. Agric. Environ. Sci. 2014, 2, 17–24. [Google Scholar] [CrossRef]
- Vitoratos, A.; Bilalis, D.; Karkanis, A.; Efthimiadou, A. Antifungal Activity of Plant Essential Oils Against Botrytis cinerea, Penicillium italicum and Penicillium digitatum. Not. Bot. Horti Agrobot. Cluj-Napoca 2013, 41, 86–92. [Google Scholar] [CrossRef]
- Barrera-Necha, L.L.; Bautista-Baños, S.; Flores-Moctezuma, H.E.; Estudillo, A.R. Efficacy of essential oils on the conidial germination, growth of Colletotrichum gloeosporioides (Penz.) Penz. and Sacc and control of postharvest diseases in papaya (Carica papaya L.). Plant Pathol. J. 2008, 5, 174–178. [Google Scholar] [CrossRef]
- Abdolahi, A.; Hassani, A.; Ghosta, Y.; Bernousi, I.; Meshkatalsadat, M. Study on the potential use of essential oils for decay control and quality preservation of tabarzeh table grape. J. Plant Prot. Res. 2010, 50, 45–52. [Google Scholar] [CrossRef]
- Ranasinghe, L.; Jayawardena, B.; Abeywickrama, K. An integrated strategy to control post-harvest decay of Embul banana by combining essential oils with modified atmosphere packaging. Int. J. Food Sci. Technol. 2005, 40, 97–103. [Google Scholar] [CrossRef]
- Azarakhsh, N.; Osman, A.; Ghazali, H.M.; Tan, C.P.; Mohd Adzahan, N. Lemongrass essential oil incorporated into alginate-based edible coating for shelf-life extension and quality retention of fresh-cut pineapple. Postharvest Biol. Technol. 2014, 88, 1–7. [Google Scholar] [CrossRef]
- Rojas-Graü, M.A.; Raybaudi-Massilia, R.M.; Soliva-Fortuny, R.C.; Avena-Bustillos, R.J.; McHugh, T.H.; Martín-Belloso, O. Apple puree-alginate edible coating as carrier of antimicrobial agents to prolong shelf-life of fresh-cut apples. Postharvest Biol. Technol. 2007, 45, 254–264. [Google Scholar] [CrossRef]
- Zarrad, K.; Ben Hamouda, A.; Chaieb, I.; Laarif, A.; Jemâa, J.M. Ben Chemical composition, fumigant and anti-acetylcholinesterase activity of the Tunisian Citrus aurantium L. essential oils. Ind. Crops Prod. 2015, 76, 121–127. [Google Scholar] [CrossRef]
- Moreno, J.R.A.; Urena, F.P.; Gonzalez, J.J.L. Conformational landscape in chiral terpenes from vibrational spectroscopy and quantum chemical calculations: S-(+)-carvone. Vib. Spectrosc. 2009, 51, 318–325. [Google Scholar] [CrossRef]
- Hayat, J.; Akodad, M.; Moumen, A.; Baghour, M.; Skalli, A.; Ezrari, S.; Belmalha, S. Phytochemical screening, polyphenols, flavonoids and tannin content, antioxidant activities and FTIR characterization of Marrubium vulgare L. from 2 different localities of Northeast of Morocco. Heliyon 2020, 6, e05609. [Google Scholar] [CrossRef]
Publisher’s Note: MDPI stays neutral with regard to jurisdictional claims in published maps and institutional affiliations. |
© 2021 by the authors. Licensee MDPI, Basel, Switzerland. This article is an open access article distributed under the terms and conditions of the Creative Commons Attribution (CC BY) license (https://creativecommons.org/licenses/by/4.0/).